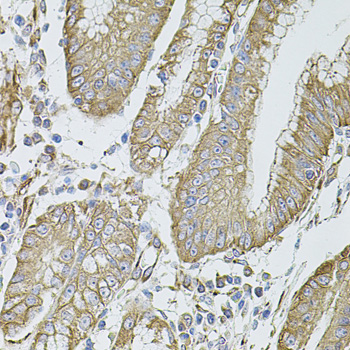
Immunohistochemistry - FLNB Polyclonal Antibody

-
Product Name
FLNB Polyclonal Antibody
- Documents
-
Description
Polyclonal antibody to FLNB
-
Tested applications
WB, IHC, IF
-
Species reactivity
Human, Mouse, Rat
-
Alternative names
FLNB antibody; ABP-278 antibody; ABP-280 antibody; AOI antibody; FH1 antibody; FLN-B antibody; FLN1L antibody; LRS1 antibody; SCT antibody; TABP antibody; TAP antibody; filamin-B antibody
-
Isotype
Rabbit IgG
-
Preparation
Antigen: Recombinant fusion protein containing a sequence corresponding to amino acids 1686-1785 of human FLNB (NP_001157789.1).
-
Clonality
Polyclonal
-
Formulation
PBS with 0.02% sodium azide, 50% glycerol, pH7.3.
-
Storage instructions
Store at -20℃. Avoid freeze / thaw cycles.
-
Applications
WB 1:500 - 1:1000
IHC 1:50 - 1:100
IF 1:20 - 1:100 -
Validations

Western blot - FLNB Polyclonal Antibody
Western blot analysis of extracts of various cell lines, using FLNB antibody at 1:1000 dilution._Secondary antibody: HRP Goat Anti-Rabbit IgG (H+L) at 1:10000 dilution._Lysates/proteins: 25ug per lane._Blocking buffer: 3% nonfat dry milk in TBST._Detection: ECL Basic Kit ._Exposure time: 10s.

Immunohistochemistry - FLNB Polyclonal Antibody
Immunohistochemistry of paraffin-embedded rat brain using FLNB antibody at dilution of 1:100 (40x lens).

Immunohistochemistry - FLNB Polyclonal Antibody
Immunohistochemistry of paraffin-embedded rat heart using FLNB antibody at dilution of 1:100 (40x lens).

Immunohistochemistry - FLNB Polyclonal Antibody
Immunohistochemistry of paraffin-embedded human liver injury using FLNB antibody at dilution of 1:100 (40x lens).

Immunohistochemistry - FLNB Polyclonal Antibody
Immunohistochemistry of paraffin-embedded human prostate using FLNB antibody at dilution of 1:100 (40x lens).

Immunohistochemistry - FLNB Polyclonal Antibody
Immunohistochemistry of paraffin-embedded human esophagus using FLNB antibody at dilution of 1:100 (40x lens).
Immunohistochemistry - FLNB Polyclonal Antibody
Immunohistochemistry of paraffin-embedded human stomach using FLNB antibody at dilution of 1:100 (40x lens).

Immunofluorescence - FLNB Polyclonal Antibody
Immunofluorescence analysis of HeLa cells using FLNB antibody at dilution of 1:100 (40x lens). Blue: DAPI for nuclear staining.

Immunofluorescence - FLNB Polyclonal Antibody
Immunofluorescence analysis of HUVEC cells using FLNB antibody at dilution of 1:100 (40x lens). Blue: DAPI for nuclear staining.

Immunofluorescence - FLNB Polyclonal Antibody
Immunofluorescence analysis of NIH/3T3 cells using FLNB antibody at dilution of 1:100 (40x lens). Blue: DAPI for nuclear staining.

Immunofluorescence - FLNB Polyclonal Antibody
Immunofluorescence analysis of PC-12 cells using FLNB antibody at dilution of 1:100 (40x lens). Blue: DAPI for nuclear staining.
-
Background
Connects cell membrane constituents to the actin cytoskeleton. May promote orthogonal branching of actin filaments and links actin filaments to membrane glycoproteins. Anchors various transmembrane proteins to the actin cytoskeleton. Interaction with FLNA may allow neuroblast migration from the ventricular zone into the cortical plate. Various interactions and localizations of isoforms affect myotube morphology and myogenesis. Isoform 6 accelerates muscle differentiation in vitro.
Related Products / Services
Please note: All products are "FOR RESEARCH USE ONLY AND ARE NOT INTENDED FOR DIAGNOSTIC OR THERAPEUTIC USE"
